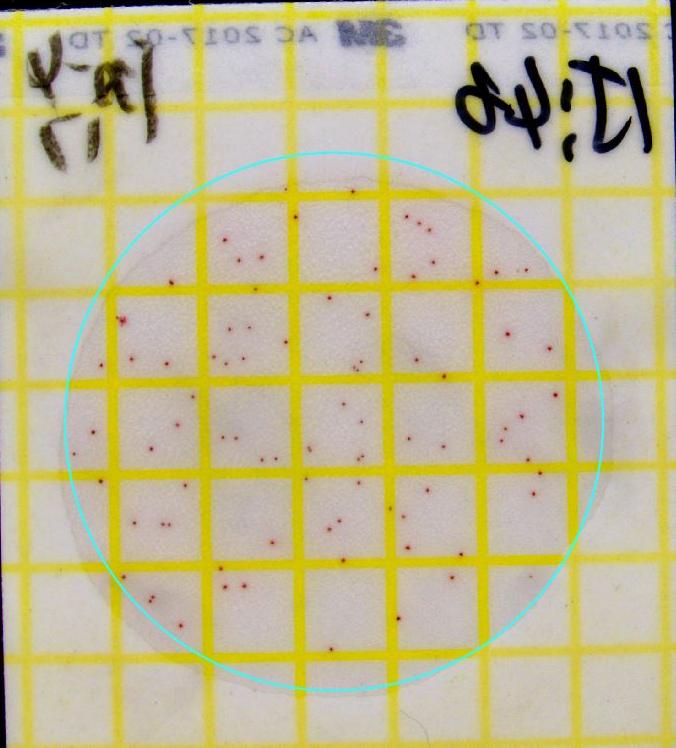
菌落總數(shù)計(jì)數(shù)前.JPG GB 4789.3下周實(shí)施!大腸菌群計(jì)數(shù)將有哪些新變化?

技術(shù)文章
GB 4789.3下周實(shí)施!大腸菌群計(jì)數(shù)將有哪些新變化?
閱讀:135 發(fā)布時(shí)間:2025-9-11《GB 4789.3-2025食品安全國家標(biāo)準(zhǔn) 食品微生物學(xué)檢驗(yàn) 大腸菌群計(jì)數(shù)》(下稱新標(biāo)準(zhǔn))將代替 GB 4789.3-2016并于2025年9月16日實(shí)施。
1、測試片法
新標(biāo)準(zhǔn)正式將大腸菌群計(jì)數(shù)測試片納入標(biāo)準(zhǔn)方法體系。
測試片法無需繁瑣的培養(yǎng)基配置步驟,操作更加簡單直觀;且測試片即開即用,大大縮短了實(shí)驗(yàn)準(zhǔn)備時(shí)間,使整個(gè)檢測流程變得更加高效。
有理論指出,在乳制品檢測中,測試片法可能比傳統(tǒng)平板法獲得更高的計(jì)數(shù)結(jié)果。因?yàn)槿橹破分锌赡艽嬖诓荒蜔峄蚴軗p的大腸菌群,傳統(tǒng)平板法在傾注過程中需要暴露于46℃左右的培養(yǎng)基中,導(dǎo)致部分敏感菌死亡;而測試片法從樣品處理到培養(yǎng)結(jié)束一直處于相對低的溫度狀態(tài),因此檢出率更高。
2、培養(yǎng)溫度
針對乳及乳制品的大腸菌群檢測,新標(biāo)準(zhǔn)將平板計(jì)數(shù)的培養(yǎng)溫度由原來的36℃±1℃修改為30℃±1℃。
大量實(shí)驗(yàn)數(shù)據(jù)發(fā)現(xiàn),乳及乳制品樣品在30℃的培養(yǎng)條件下,計(jì)數(shù)結(jié)果均顯著高于36℃的培養(yǎng)數(shù)值;而且國際上的乳制品微生物檢測標(biāo)準(zhǔn)也普遍采用低于36℃的培養(yǎng)溫度。
3、菌落挑取
GB 4789.3-2016規(guī)定,挑取10個(gè)不同類型的典型和可疑菌落。
GB 4789.3-2025進(jìn)一步明確規(guī)定,挑取典型和可疑菌落各5個(gè),典型或可疑菌落少于5個(gè)者,挑取全部菌落。這一變化使操作規(guī)范更加清晰,減少了不同實(shí)驗(yàn)室間的操作差異。
大微方案:

DW-V系列 全自動(dòng)菌落計(jì)數(shù)儀
儀器用于微生物菌落的快速讀數(shù)和統(tǒng)計(jì),全自動(dòng)運(yùn)行,支持多種菌落形態(tài)的自動(dòng)統(tǒng)計(jì)。同時(shí)軟件具備智能識(shí)別技術(shù),可對平皿上所有菌落進(jìn)行高通量表型分析,包括菌落大小、圓度、表型形態(tài)、邊緣特性等。

產(chǎn)品優(yōu)勢:
1、效率高:一鍵完成菌落計(jì)數(shù),統(tǒng)計(jì)平板/測試片上所有菌落僅需1秒;


大腸菌群測試片上機(jī)識(shí)別結(jié)果圖

菌落總數(shù)測試片上機(jī)識(shí)別結(jié)果圖
2、重復(fù)度高:計(jì)數(shù)結(jié)果標(biāo)準(zhǔn)化且重復(fù)度高;


3、模式多樣:支持不同類型平板,多種模式可供選擇;

大腸菌群作為食品衛(wèi)生安全的關(guān)鍵指標(biāo)菌,其檢測結(jié)果直接影響企業(yè)對產(chǎn)品質(zhì)量的把控和監(jiān)管部門的執(zhí)法決策。此次修訂不僅實(shí)現(xiàn)了與國際標(biāo)準(zhǔn)的進(jìn)一步接軌,更在檢測流程與結(jié)果報(bào)告方面實(shí)現(xiàn)了操作更靈活、方法更簡便、效率更高效的全面提升。
 化工儀器網(wǎng)
化工儀器網(wǎng)